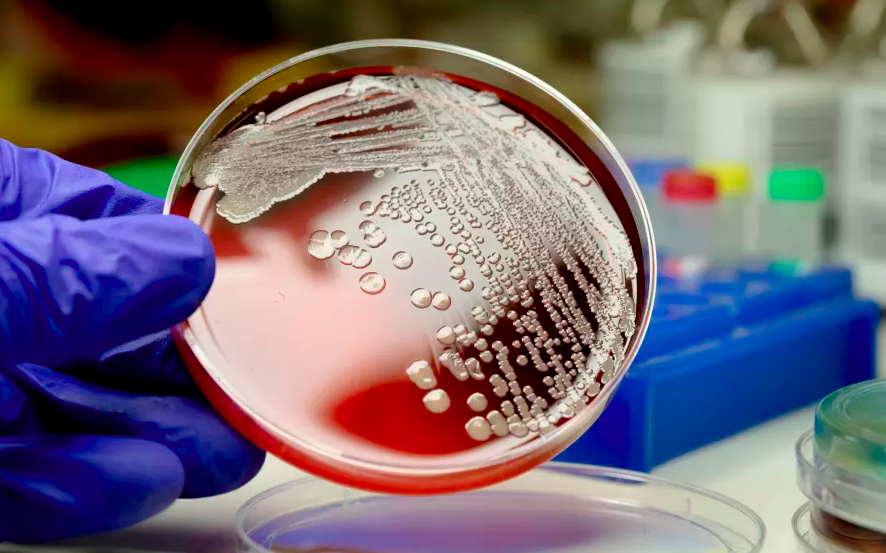

En hospitales de todo el mundo se ha esparcido un microorganismo patógeno conocido como Staphylococcus epidermidis o S. epidermis, que puede provocar infecciones serias e invasivas en una cantidad reducida de personas.
La revista Nature Microbiology, publicó un estudio el pasado tres de septiembre, que indica que se analizaron muestras recogidas en 78 instituciones médicas de 10 países diferentes, con las que se determinó la presencia del microbio que suele colonizar la piel.
El S. epidermis ha desarrollado una resistencia a la mayoría de los antibióticos. Al respecto, el experto Ben Howden, explicó que “con todas las bacterias presentes en los ambientes hospitalarios, estamos impulsando cepas más resistentes”.
La evolución de este organismo pudo deberse a la prescripción inapropiada de antibióticos en las unidades de cuidados intensivos.
Con información de RT
 Yucatán al Instante Noticias al Instante
Yucatán al Instante Noticias al Instante